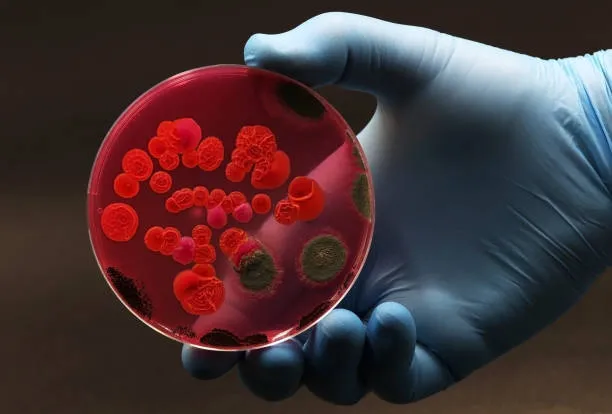
istockphoto-1497892050-612x612

Descubren células clave del sistema inmune que combaten la Candida, un hongo que provoca infecciones severas
Ciencia y Tecnología19/11/2024 Raudy Mota
Raudy Mota
De todos los hongos que viven en el cuerpo humano, el más infame es probablemente la levadura Candida. Este primo lejano de la levadura de panadería es conocido por causar varios tipos de candidiasis que pueden ser una gran molestia, pero también pueden provocar una infección invasiva que, en ocasiones, puede resultar fatal.
En un estudio publicado en Nature Immunology, un equipo de investigación del Instituto Weizmann de Ciencias dirigido por el profesor Jakub Abramson descubrió un mecanismo de defensa previamente desconocido que emplea el sistema inmunológico para combatir las infecciones por Candida.
La Candida está presente en niveles bajos en el cuerpo de la mayoría de las personas sanas y forma parte del microbioma, un espectro diverso de microbios que residen pacíficamente en nuestro intestino y en nuestra piel. En circunstancias normales, el sistema inmunológico mantiene a raya a la Candida, pero en ocasiones puede crecer excesivamente e invadir el revestimiento de la boca, la vagina, la piel u otras partes del cuerpo.
En casos graves, puede propagarse al torrente sanguíneo y de allí a los riñones. Estas infecciones potencialmente mortales pueden ocurrir cuando el sistema inmunológico de una persona se ha debilitado, por ejemplo, por el SIDA o por medicamentos inmunosupresores como la quimioterapia contra el cáncer o los esteroides.
os antibióticos, que eliminan muchas de las bacterias beneficiosas de nuestro microbioma, también pueden desencadenar erupciones locales o invasivas de Candida al proporcionar a esta levadura una ventaja injusta frente a otros microorganismos. Por eso, por ejemplo, a veces las mujeres desarrollan una candidiasis vaginal después de tomar antibióticos.
Hasta ahora, las células inmunes que se llevaban la mayor parte del crédito por defensor al cuerpo contra la Candida eran los linfocitos pequeños y redondos del tipo de célula T, llamados TH 17. Estas células también eran las que cargaban con la culpa cuando esta defensa fallaba.
En el nuevo estudio, el investigador postdoctoral doctor Jan Dobeš, trabajando junto con colegas del laboratorio de Abramson en el Departamento de Inmunología y Biología Regenerativa de Weizmann, descubrió que no se puede generar una poderosa unidad de comando de células TH 17 capaces de combatir Candida sin el apoyo temprano crucial de un contingente completamente diferente: un subconjunto de células linfoides raras conocidas como células linfoides innatas tipo 3, o ILC3, que expresan un gen llamado regulador autoinmune, o Aire.
Los dos grupos de células pertenecen a dos brazos diferentes del sistema inmunitario, que, como patrullas a pie y unidades especializadas, unen sus fuerzas contra un enemigo común. Las Aire-ILC3, parte del brazo innato más antiguo, entran en acción casi de inmediato al encontrarse con una amenaza, en este caso, una infección por Candida. Las TH 17 pertenecen al brazo adaptativo más reciente del sistema inmunitario, que tarda varios días o incluso semanas en responder, pero que lanza un ataque mucho más específico y potente que el innato.
Los científicos descubrieron que, tan pronto como Candida comienza a infectar los tejidos, las Aire-ILC3 engullen la levadura entera, la cortan en pedazos y muestran algunos de los trozos de levadura en sus superficies.
Así es como estos trozos se presentan a las células T 17, algunas de las cuales generalmente están de guardia en los ganglios linfáticos, listas para una alerta de infección. Este tipo de presentación ordena a las células T especializadas que comiencen a dividirse rápidamente, aumentando en número desde unos pocos comandos solitarios hasta varios cientos o incluso miles de combatientes específicos de Candida, capaces de destruir la levadura en los sitios de infección.
“Hemos identificado un arma del sistema inmunológico previamente desconocida que es indispensable para orquestar una respuesta efectiva contra la infección fúngica”, dice Abramson.
Abramson se sintió intrigado por la Candida porque suele provocar infecciones crónicas y graves en personas con un síndrome autoinmune poco común causado por defectos en el gen Aire. El laboratorio de Abramson había realizado estudios exhaustivos de este gen, lo que ayudó a aclarar su papel en la prevención de trastornos autoinmunes.
Esa investigación, así como los estudios de otros científicos, habían demostrado que las células que expresan Aire en el timo dan instrucciones a las células T en desarrollo para que se abstengan de atacar los propios tejidos del cuerpo. Cuando Aire es defectuoso, las células T no reciben las instrucciones adecuadas, lo que provoca una autoinmunidad generalizada que causa estragos en múltiples órganos del cuerpo. Pero quedaba un enigma: ¿Por qué los pacientes con deficiencia de Aire que sufren un síndrome autoinmune devastador también desarrollan infecciones crónicas por Candida?
Mientras intentaban completar el rompecabezas de Aire, Dobeš y sus colegas descubrieron que, fuera del timo, Aire también se expresa en un pequeño subconjunto de ILC3 en los ganglios linfáticos. Luego, los investigadores diseñaron genéticamente dos grupos de ratones: uno carecía de Aire en el timo y el otro grupo carecía de él en los ILC3 de los ganglios linfáticos.
El primer grupo desarrolló autoinmunidad, pero pudo combatir con éxito a Candida. En cambio, los del segundo grupo, los que carecían de Aire en los ILC3, no sufrieron autoinmunidad, pero no pudieron generar numerosos Th 17 específicos de Candida. En consecuencia, no lograron eliminar eficazmente las infecciones por Candida. En otras palabras, sin ILC3 que expresaran Aire, las células T especializadas necesarias para combatir Candida no se produjeron en cantidades suficientes.
“Encontramos un papel completamente nuevo para Aire, que desempeña en los ganglios linfáticos: activa un mecanismo que aumenta la cantidad de células T que combaten a Candida”, explica Dobeš.
Estos hallazgos abren nuevas vías de investigación que en el futuro podrían ayudar a desarrollar nuevos tratamientos para la Candida grave y posiblemente para otras infecciones fúngicas. El mecanismo recién descubierto podría, por ejemplo, ayudar a producir grandes cantidades de células T que combatan la Candida para ser utilizadas en terapias celulares. Y si algún día los científicos identifican las señales por las que Aire-ILC3 estimula la proliferación de células T, estas señales podrían proporcionar la base para nuevas terapias.
Los participantes del estudio incluyeron al Dr. Jan Dobeš, la Dra. Katarína Kováčová, la Dra. Helena Böhmová, y el Dr. Dominik Filipp del Instituto de Genética Molecular de la Academia Checa de Ciencias; el Dr. Osher Ben-Nun, el Dr. Amit Binyamin, la Dra. Liat Stoler-Barak, la Dra. Yael Goldfarb, el Dr. Noam Kadouri, la Dra. Yael Gruper, el Dr. Tal Givony, el Dr. Itay Zalayat, el Dr. Ziv Shulman y el Prof. Jakub Abramson del Departamento de Inmunología y Biología Regenerativa del Instituto Weizmann de Ciencias; y la Dra. Bergithe E. Oftedal y el Dr. Eystein S. Husebye de la Universidad de Bergen y el Hospital Universitario Haukeland en Noruega.
INFOBAE







Embajadora de EE. UU. en RD se une en oración por víctimas del Jet Set











